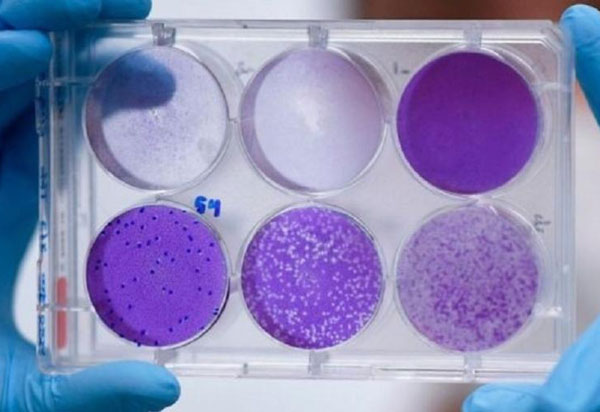
Cientistas brasileiros preparam teste de medicamento que reduz carga viral  da Covid-19 em 94%

Um projeto de Lei que tramita na Assembleia Legislativa da Bahia (Alba) propõe que deverá ser feriado no dia 12 de dezembro (sábado) e pontos facultativos nos dias 10 e 11, quinta e sexta-feira respectivamente, para nesta data sejam realizados os festejos tradicionalmente realizados no mês de junho. De acordo com informações do BNews, o deputado estadual Marcell Moraes (PSDB), autor da proposição, afirma que a Bahia perde um importante momento para aquecer a economia. “As cidades de pequeno e médio porte do interior são beneficiadas de forma direta ou indireta, por que há mais pessoas circulando pelas estradas, procurando casas para alugar ou hotéis, além da alimentação e outros. São muitos setores envolvidos e com lucro. Por prudência por causa da pandemia, infelizmente, toda essa dinâmica será prejudicada”, disse. Devido à pandemia do novo coronavírus (Covid-19), diversas cidades baianas anunciaram o cancelamento das festas de São João. No último dia 09 de abril, prefeitos de várias cidades firmaram um acordo para cancelar os festejos, seguindo “recomendação administrativa do Ministério Público de Contas do Estado da Bahia, que recomenda aos municípios baianos a não realizar festejos juninos ou evento de qualquer natureza utilizando recursos públicos durante o período de combate à COVID-19”.
SESI Bahia tem 400 vagas gratuitas em Brumado para Educação de Jovens e Adultos
17 Abr 2020 // 08:57 Wilker Porto | Agora Sudoeste
O Serviço Social da Indústria (SESI Bahia) oferece oportunidade para jovens e adultos retomarem seus estudos gratuitamente. Até 30 de maio, a instituição estará com inscrições abertas para 2.850 vagas no Ensino Fundamental II (6º ao 9º ano) e no Ensino Médio (1º ao 3º ano) para quem tem mais de 18 anos. Os cursos são realizados na modalidade a Distância (EaD) e as oportunidades são para os Polos EJA SESI nas cidades de Juazeiro, Luís Eduardo Magalhães, Brumado (400 vagas), Vitória da Conquista, Teixeira de Freitas, Ilhéus e Salvador. As inscrições devem ser feitas pelo site do SESI Bahia (www.fieb.org.br/sesi). O SESI Bahia é a única instituição no estado que oferece o ensino médio e fundamental II a distância, com oferta autorizada pelo Ministério da Educação. O curso também é reconhecido pelo Conselho Estadual de Educação. Além disso, o SESI Bahia possui a metodologia de Reconhecimento de Saberes que identifica, valida e certifica as competências e habilidades desenvolvidas nas experiências de vida e trabalho do estudante. A principal vantagem é que o reconhecimento dos conhecimentos prévios do aluno diminui o tempo de curso, ao focar nas competências essenciais que o estudante precisa dominar para concluir o ensino fundamental ou médio.

A Secretaria da Saúde do Estado da Bahia (Sesab) informa que registrou, nesta quinta-feira (16), o 35º óbito pelo novo coronavírus (Covid-19) no estado. A morte foi de um homem de 28 anos, residente em Lauro de Freitas, com histórico de obesidade. Ele estava internado em um hospital público na capital baiana, vindo a falecer.
Bolsonaro defende retomada gradual das atividades no Brasil
17 Abr 2020 // 01:28 Agência Brasil
O presidente Jair Bolsonaro disse nesta quinta-feira (16), durante sua live semanal no Facebook, que a nova diretriz do Ministério da Saúde será pela retomada gradativa do comércio e do fim do isolamento social no país, mas que a decisão cabe aos governadores e prefeitos. "Não vai ser de uma hora pra outra, não vai ser um cavalo de pau, mas nós entendemos que, paulatinamente, com muita responsabilidade, o Brasil tem que começar a trabalhar. Agora, a decisão vai partir muito mais dos governadores e dos prefeitos, porque essa foi a decisão do Supremo Tribunal Federal, se não me engano, por unanimidade, no dia de ontem", disse o presidente. Na decisão citada por ele, os ministros da Suprema Corte definiram que estados e municípios têm autonomia para tomar as medidas que acharem necessárias para combater o novo coronavírus, como isolamento social, fechamento do comércio e outras restrições. Ao lado do novo ministro da Saúde, Nelson Teich, Bolsonaro voltou a argumentar, durante a live, que uma quarentena "rígida" pode causar problemas irreversíveis na economia. "Nós sabemos que o efeito colateral de uma quarentena muito rígida, fazendo com que as pessoas mais humildes viessem a perder seu emprego, ou seu ganha-pão, no caso da informalidade, poderia ocasionar problemas seríssimos para o Brasil, a ponto de a economia não se recuperar mais". Nelson Teich reforçou que o foco a pasta será no mapeamento do avanço na doença do país. "Agora a gente tem que ter um foco muito grande em colher dados sobre qual é a prevalência dessa doença, seja dos infectados, seja dos que [se] curaram e dos que morreram. Quando a gente combinar esses dados, vai ser muito mais fácil a gente enxergar o que acontece e traçar políticas e ações", disse. Um dos objetivos do novo ministro é justamente deflagrar um programa de testagem em massa da população. Nelson Teich, que é médico oncologista, assume o lugar do ortopedista Luiz Henrique Mandetta, que ficou 16 meses à frente da pasta.
Brumado tem 10 novos Casos notificados do Novo Coronavírus
16 Abr 2020 // 17:33 Wilker Porto | Agora Sudoeste
A Secretaria Municipal de Saúde de Brumado informou nesta quinta-feira (16) que os casos notificados do Novo Coronavírus, em Brumado aumentaram de 484 para 494. Trinta e seis casos suspeitos foram descartados. Dos 08 confirmados até agora sete foram curados. 14 aguardam resultado e até o momento ninguém foi hospitalizado. A Secretaria de Saúde informa que todas as medidas de prevenção ao contágio do vírus tem que serem tomadas pela população.
Ministro da Saúde Luiz Henrique Mandetta é demitido pelo presidente Jair Bolsonaro
16 Abr 2020 // 16:34
O ministro da Saúde, Luiz Henrique Mandetta comunicou nesta quinta-feira (16) , em uma rede social, que foi demitido pelo presidente Jair Bolsonaro."Acabo de ouvir do presidente Jair Bolsonaro o aviso da minha demissão do Ministério da Saúde. Quero agradecer a oportunidade que me foi dada, de ser gerente do nosso SUS, de pôr de pé o projeto de melhoria da saúde dos brasileiros e de planejar o enfrentamento da pandemia do coronavírus, o grande desafio que o nosso sistema de saúde está por enfrentar", escreveu Mandetta. "Agradeço a toda a equipe que esteve comigo no MS e desejo êxito ao meu sucessor no cargo de ministro da Saúde. Rogo a Deus e a Nossa Senhora Aparecida que abençoem muito o nosso país", prosseguiu. De acordo com informações do G1, ex-deputado federal, Mandetta estava à frente da pasta desde o início do governo, em janeiro de 2019, e ganhou maior visibilidade com a crise provocada pelo novo coronavírus. Na tarde desta quinta, Mandetta foi chamado ao Planalto para uma última reunião com Jair Bolsonaro. Nas últimas semanas, contudo, Bolsonaro e Mandetta tiveram divergências públicas em razão das estratégias para conter a velocidade do contágio da Covid-19, doença provocada pelo vírus.Em coletiva nesta quarta (15), no Palácio do Planalto, o então ministro da Saúde disse que era claro o "descompasso" entre a pasta e as orientações do presidente Jair Bolsonaro. Segundo Mandetta, pessoas cotadas para a sucessão no cargo chegaram a ligar para ele em busca de aconselhamento. Na entrevista, o ministro também disse que a equipe montada por ele e empossada em 2019 trabalharia em conjunto, e ajudaria na transição para evitar uma ruptura na política contra a Covid-19.

A Secretaria da Saúde do Estado da Bahia (Sesab) informa que registrou, nesta quinta-feira (16), o 33º óbito pelo novo coronavírus (Covid-19) no estado. A morte foi de uma mulher de 82 anos, residente em Lauro de Freitas, com histórico de doença cardiovascular. Ela estava internada em um hospital particular na capital baiana desde 14 de abril, vindo a falecer hoje.
Brumado: CDL disponibiliza acesso gratuito ao sistema de conteúdos e plataforma de ensino 'HSM Experience'
16 Abr 2020 // 15:50 Wilker Porto | Agora Sudoeste
A Câmara de Dirigentes Lojistas (CDL) de Brumado está disponibilizando aos seus associados, através do sistema CNDL, acesso ao sistema de conteúdos e plataforma de ensino “HSM Experience”. "Entendemos que a informação é a nossa maior ferramenta em momentos de tamanha incerteza. Para fazer o cadastro basta estar munido das seguintes informações: nome completo, e-mail válido, telefone, informar a CDL a qual é filiado (CDL de Brumado), código de associado (disponível na fatura). Clique no link a seguir e aproveite o período de gratuidade até o dia 31/05/2020: https://bit.ly/2XlmctH", informa a direção da CDL.
Chapada Diamantina: Operação localiza quadrilha que praticava sequestros
16 Abr 2020 // 15:17 Wilker Porto | Agora Sudoeste
Seis criminosos foram localizados durante ação conjunta das polícias Militar e Civil realizada na manhã desta quarta-feira (15), nos municípios de Lapão, Carfanaum, Bonito e Souto Soares, situados na região da Chapada Diamantina. O bando atuava com extorsão mediante sequestro em Irecê e municípios adjacentes e foi encontrado durante cumprimentos de mandados de prisão expedidos pela Vara Criminal da comarca de Lapão. "Eles possuem envolvimento com alguns crimes desta modalidade ocorridos em 2019 e em março deste ano. Preparamos as equipes e, em parceria com PM, conseguimos localizar maior parte da quadrilha", contou o coordenador da 14ª Coordenadoria Regional de Polícia do Interior (Coorpin/Irecê), delegado Almir Fernandes. "Na ação, quatro criminosos foram capturados e encaminhados à 14ª Coorpin. Outros dois comparsas resistiram a prisão atirando contra as equipes, ficaram feridos e não resistiram. Um revólver calibre 38, uma espingarda calibre 12 e munições foram apreendidos", disse o comandante da Cipe Semiárido, major Carlos Maltez. Participaram da operação integrantes das 13ª e 14ª Coorpins, do Departamento de Repressão e Combate ao Crime Organizado (Draco), da Coordenação de Operações Especiais (COE), das Companhias Independentes de Policiamento Especializado (Cipes Semiárido e Chapada), do 7º Batalhão da PM e da Rondesp Chapada.
Brumado: vereador Santinho diz que 'há pessoas recebendo cestas básicas sem necessidade'
16 Abr 2020 // 14:53 Wilker Porto | Agora Sudoeste
O vereador José da Silva Santos (PSB), o "Santinho", líder do prefeito Eduardo Lima Vasconcelos na Câmara de Vereadores de Brumado, afirmou que há pessoas - que não estão em vunerabilidade social, recebendo as cestas básicas disponibilizadas como auxílio emergencial a famílias carentes durante a Pandemia da Covid-19. O pronunciamento do vereador ocorreu na manhã desta terça-feira (13), durante sessão do Legislativo, mas o mesmo não citou nominalmente quem seriam as pessoas que estariam recebendo o benefício sem necessidade. “Se todos os alunos do município precisam? Eu acho que não! A maioria precisa sim, mas alguns não. Tem pessoas que estão recebendo e não precisam, eu conheço alguns. Infelizmente, alguns vão ficar sem receber por conta dos chamados espertalhões”, disse o edil.
Bahia regista 951 casos confirmados de Covid-19 e chega ao 31º óbito
16 Abr 2020 // 13:26 Wilker Porto | Agora Sudoeste
A Bahia registra 951 casos confirmados do novo coronavírus (Covid-19), sendo 102 profissionais de saúde. Até o momento, 5.268 casos foram descartados e houve 31 óbitos, sendo 16 no município de Salvador e 15 nos municípios de Lauro de Freitas (2), Gongogi (1), Itapetinga (1), Utinga (1), Adustina (1), Araci (1), Itagibá (1), Uruçuca (2), Ilhéus (2), Belmonte (1), Vitória da Conquista (1) e Itapé (1). A 29ª morte foi de um homem de 62 anos, residente em Uruçuca, com histórico de hipertensão e tabagismo. Já o 30º óbito foi de uma mulher de 61 anos, residente em Ilhéus, com histórico de doença renal crônica, hipertensão e pneumonia. Ambos estavam internados em um hospital público em Ilhéus e tiveram o registro de óbito nesta quinta-feira.Já o 31º falecimento foi de uma mulher de 90 anos, residente em Salvador, com comorbidades associadas, a exemplo de obesidade e doença renal crônica. Ela estava internada em um hospital público em Salvador e foi a óbito ontem (15). Este número contabiliza todos os registros de janeiro até as 12 horas desta quinta-feira (16). Ao todo, 250 pessoas estão recuperadas e, do total de casos confirmados, 104 encontram-se internados, sendo 45 em UTI. Estes dados representam notificações oficiais compiladas pelo Centro de Informações Estratégicas em Vigilância em Saúde da Bahia (Cievs-BA), em conjunto com os Cievs municipais.
SMTT vai dinamizar atividades em prol do aprimoramento do trânsito em Brumado
16 Abr 2020 // 12:53 Wilker Porto | Agora Sudoeste
A SMTT – Superintendência Municipal de Trânsito e Transportes de Brumado, através da Coordenação de Fiscalização e Controle determinou a fiscalização ostensiva das vias da sede do Município de Brumado. Assim os agentes de trânsito foram convocados, inclusive os da área administrativa, para o desenvolvimento de suas atividades regulares na via, conforme escala publicada em mural da instituição. O coordenador da fiscalização, João Paulo Rocha, esteve na manhã desta quarta-feira (15) reunido com o coordenador educacional Jansen Malheiro para delinear as necessidades de controle viário, estacionamento e fluidez. Na reunião foi destacada a importância do papel do agente de trânsito no desenvolvimento estratégico e viário no município, especialmente com ações voltadas à Educação no Trânsito. As atividades do órgão, a equipe de agentes de fiscalização estará nas ruas ostensivamente a partir desta quinta-feira (16) em locais específicos para colocar em prática as ações e também auxiliar e orientar a população.
STF decide que governadores e prefeitos estão livres para adotar medidas de isolamento social
16 Abr 2020 // 11:30 Wilker Porto | Agora Sudoeste
O Supremo Tribunal Federal (STF) decidiu, por nove votos a zero, que estados e municípios possuem autonomia para regulamentar as medidas de isolamento social. Os ministros Marco Aurélio Mello, Alexandre de Moraes, Edson Fachin, Rosa Weber, Luiz Fux, Cármen Lúcia, Ricardo Lewandowski, Gilmar Mendes e o presidente da Corte, Dias Toffoli, votaram a favor da proposta. Celso de Mello e Luis Roberto Barroso não votaram. Para os magistrados, o governo federal tem autonomia apenas para definir os serviços essenciais e as atividades de interesse nacional. A interpretação é de que estados e municípios podem regulamentar quais serviços podem parar ou continuar em seus territórios. A discussão foi levada à Corte pelo PDT, após o governo federal publicar uma medida provisória que restringia a ação de governadores durante a pandemia do novo coronavírus. A ação questionava trechos da MP que deixavam a cargo da União a definição de quais serviços essenciais deveriam ficar abertos, independentemente de medidas de isolamento adotadas por governadores e prefeitos.
Brumado: barragem de Cristalândia volta a sangrar pela terceira vez este ano
16 Abr 2020 // 11:01 Janine Andrade | Agora Sudoeste
A barragem de Cristalândia, que abastece os municípios de Brumado e Malhada de Pedras, sangrou pela terceira vez esse ano. Os quatros primeiros meses de 2020 foram de muitas chuvas em toda região e com isso o manancial que já estava com sua capacidade máxima, que é de 17 milhões de m³ de água, voltou a verter. A lâmina d'água está em 45cm.
Caixa paga hoje auxílio emergencial a 3,6 milhões de beneficiários
16 Abr 2020 // 10:27 Agência Brasil
A Caixa Econômica Federal paga hoje (16) a primeira parcela do auxílio emergencial de R$ 600 a 2.282.321 de pessoas com as informações em dia no Cadastro Único de Programas Sociais (CadÚnico). Hoje também começa a ser feito o pagamento a beneficiários do programa Bolsa Família. Serão 1.360.024 beneficiários do programa de transferência de renda. No caso dos trabalhadores informais, o pagamento será para as pessoas nascidas em maio, junho, julho e agosto, por meio de crédito em poupança digital. Amanhã (17) será feito o crédito para 1.958.268 de pessoas nascidas em setembro, outubro, novembro e dezembro. A Caixa informou que até as 17h de ontem, 36,3 milhões de cadastros foram finalizados. Foram creditados R$ 3,2 bilhões a 4,9 milhões de pessoas.
Brumado contabiliza 42 casos confirmados de dengue
16 Abr 2020 // 09:58 Wilker Porto | Agora Sudoeste
Os casos de dengue têm aumentado assustadoramente na cidade de Brumado. Segundo informações apuradas pelo Agora Sudoeste junto à secretaria de saúde do município, são 42 casos confirmados da doença. A cidade está em estado de alerta e atualmente conta com 25 agentes de endemias para atender todo o município. Ainda de acordo com informações da secretaria, foi solicitado um carro fumacê para fazer a dedetização dos bairros.
SAAE isentará, por 60 dias, pagamento de contas para os consumidores na categoria residencial em Dom Basílio
16 Abr 2020 // 09:45 Janine Andrade | Agora Sudoeste
Diante da crise em decorrência da Covid-19, o Serviço Autônomo de Água e Esgoto de Dom Basílio (SAAE) isentará munícipes do pagamento da conta de água , pelos próximos 60 dias, das faturas referentes a abril e maio. A medida vale para os consumidores na categoria residencial, com consumo mensal de até 10 M³. A empresa recomenda que os cidadãos beneficiados utilizem a água com moderação e consciência para evitar o desperdício, restringindo-se ao que for realmente necessário como consumo, higienização pessoal e das residências. A medida integra o Decreto Municipal nº 039/2020, de 13 de abril, que dispõe sobre medidas adicionais temporárias de prevenção e controle para enfrentamento do novo Coronavírus.
Disbahia: adquira álcool gel 70% de 5l ou 500ml
16 Abr 2020 // 09:12 Janine Andrade | Agora Sudoeste
Exploração de pedras jaspe por chineses em nascente de rio em comunidade de Contendas do Sincorá é denunciada por moradores
16 Abr 2020 // 08:41
Há quatro meses, uma região da comunidade Palmeiras, no município de Contendas do Sincorá, região da Chapada Diamantina, têm sido degradada pela exploração de pedras jaspe sem autorização de órgãos ambientais e sem licenças. Conforme denúncia de moradores, enviada ao Jornal da Chapada, a exploração ocorre também próximo a uma nascente de rio, adjacente a Cachoeira de Jambinha. De acordo com a reportagem, a área foi vendida por um atual vereador de Ibicoara a um grupo de chineses, que reside em Ituaçu – região na fronteira com povoado de Palmeiras – e tem como objetivo apenas a extração do mineral. Ainda segundo informações, a medida oferece risco ao manancial que abastece o povoado de Palmeiras, pois as atividades desencadeia desmatamento da mata ciliar – importante para a biodiversidade de uma nascente de rio e o assoreamento do afluente. “Eles fazem uso de retroescavadeira, explosivos, motosserras. E o secretário de Agricultura e Meio Ambiente do município, visitou a localidade e deu o prazo 15 dias para eles apresentarem os documentos que comprovem a atividade. No entanto, isso será improvável, pois eles agem de maneira fraudulenta”, ressaltou um denunciante ao Jornal da Chapada. “Apesar de ter vendido a propriedade aos chineses, o vereador de Ibicoara mantém um certo vínculo com eles. Ele esteve na propriedade um dia depois de nosso comparecimento nesta localidade para questionara as ações. O vereador veio até o povoado de Palmeiras, tentando descontextualizar as informações, para alguns moradores, dizendo que as fotos eram fake news, minimizando os danos ambientais praticados pelos chineses”, disse outro denunciante. O Jornal da Chapada manteve contato com o secretário de Agricultura e Meio Ambiente, Adalberto Oliveira, para mais informações dos fatos. O secretário aponta que a prefeitura e a pasta têm tomado as medidas cabíveis ao que se restringem o Código Municipal Ambiental. “Foi realizada uma visita prévia ao local, e constatado de fato a exploração de jazida, aparentemente sem nenhuma autorização de algum órgão competente. Em seguida, fizemos a notificação para que a documentação fosse apresentada em um prazo de 15 dias. Junto a esse fato, foi também verificado um barramento feito com sacos de areia para desvio de parte da água de seu curso natural”, afirmou o secretário, o qual complementou: “Mas posso adiantar que mesmo que seja apresentada alguma documentação autorizando a exploração ela será reavaliada, porque o local é uma área de preservação permanente. Temos uma parceria com o Instituto Chico Mendes de Conservação da Biodiversidade [ICMBio] e assim que cumprindo o prazo da notificação estaremos encaminhado o processo para o Instituto do Meio Ambiente e Recursos Hídricos [Inema] e Ministério Público [MP-BA]”.
Bahia tem 884 casos confirmados de Covid-19
16 Abr 2020 // 08:14 Wilker Porto | Agora Sudoeste
A Bahia registra 884 casos confirmados do novo coronavírus (Covid-19), o que representa 8,86% do total de casos notificados. Até o momento, 5267 casos foram descartados e houve 28 óbitos, sendo 15 no município de Salvador e 13 nos municípios de Lauro de Freitas (2), Gongogi (1), Itapetinga (1), Utinga (1), Adustina (1), Araci (1), Itagibá (1), Uruçuca (1), Ilhéus (1), Belmonte (1), Vitória da Conquista (1) e Itapé (1). Um caso confirmado que anteriormente havia sido notificado como Bom Jesus da Lapa, tem como registro do provável local de infecção a cidade de Salvador. Um dos óbitos que estava sendo registrado em Ilhéus, é de uma paciente residente em Itapé. Este número contabiliza todos os registros de janeiro até as 17 horas desta quarta-feira. Ao todo, 218 pessoas estão recuperadas e 99 encontram-se internadas, sendo 38 em UTI. Estes dados representam notificações oficiais compiladas pelo Centro de Informações Estratégicas em Vigilância em Saúde da Bahia (Cievs-BA), em conjunto com os Cievs municipais. Os casos confirmados estão distribuídos em 83 municípios do estado, com maior proporção em Salvador (58,71%). Quanto ao sexo dos casos confirmados, 494 (55,88%) foram do sexo feminino. A mediana de idade foi 42 anos, variando de 4 dias a 96 anos. A faixa etária mais acometida foi a de 30 a 39 anos, representando 28,28% do total. O coeficiente de incidência por 1.000.000 habitantes também foi maior nesta faixa etária (108,97/ 1.000.000 habitantes), indicando que o risco de adoecer passou a ser maior entre os adultos jovens, seguida da faixa de 50 a 59 anos (101,83/ 1.000.000 habitantes).
Brumado tem 07 pessoas curadas do Novo Coronavírus
15 Abr 2020 // 17:54 Wilker Porto | Agora Sudoeste
A secretaria municipal de saúde de Brumado divulgou nesta quarta-feira (15) novo boletim informativo do Coronavírus. Até o momento são 484 casos notificados para COVID-19. Dos 08 casos confirmados sete já foram curados. Há 35 casos descartados, 11 aguardando resultado e nenhum óbito confirmado até o momento.
Cientistas brasileiros preparam teste de medicamento que reduz carga viral da Covid-19 em 94%
15 Abr 2020 // 17:36
Conforme anúncio feito pelo ministro da Ciência, Tecnologia, Inovações e Comunicações, Marcos Pontes, nesta quarta-feira (15), pesquisadores do CNPEM (Centro Nacional de Pesquisa em Energia e Materiais) descobriram em testes laboratoriais que um medicamento reduz em até 94% a carga viral do novo coronavírus. De acordo com informações da BBC News Brasil, em São Paulo, os pesquisadores não vão revelar o nome do medicamento até que os testes clínicos em pacientes com Covid-19 comprovem a eficácia, mas disseram que o medicamento tem baixo custo, ampla distribuição em farmácias brasileiras e não tem efeitos colaterais graves.
Brumado: alunos da rede estadual de ensino têm direito a Auxílio Alimentação; acesse o link e se inscreva para receber o benefício
15 Abr 2020 // 16:58 Janine Andrade | Agora Sudoeste
O Colégio Estadual de Brumado (CEB) informa aos pais e alunos que, devido ao quadro de isolamento e suspensão das aulas causada pela pandemia, o Governo do Estado disponibilizará um Auxilio Alimentação para todos os alunos da rede estadual. Para ter direito a esse auxílio, é necessário quer o aluno ou responsável tenha em mãos o CPF, RG e número de matrícula do aluno e acesse o link SIADIANTE siadiante.educacao.ba.gov.br/login para cadastro. “Nós, do CEB, também precisamos de informações a seu respeito e sobre as atividades remotas (virtuais) que estão sendo desenvolvidas durante a quarentena. Para respondê-lo acesse http://formas.gle/xviewK68vTEUzNFJ7. Qualquer dúvida entre em contato com os telefones: 77 9.9972-7677 - Professora Najla Martins ou 77 9.9941-4450 - Professora Vanusia Caires”, informa a diretoria do CEB.
Brumado: homem troca tiros com a polícia, abandona veículo e foge durante abordagem
15 Abr 2020 // 16:28 Janine Andrade | Agora Sudoeste
Durante rondas de rotina na Rua Princesa Isabel, no Bairro Malhada Branca, em Brumado, na noite desta terça feira (15), a Polícia Militar percebeu um carro com vidros fumê em situação suspeita. Ao perceber a presença da viatura policial, o motorista tentou fugir, mas foi interceptado. Ao descer do carro para ser abordado, o suspeito empreendeu fuga, sacou uma arma e atirou contra os policiais. Houve revide a injusta agressão, e o homem conseguiu fugir do local. De acordo com informações da polícia, o veículo no qual estava o suspeito estava ligado sem chave, em ligação direta, e dentro de uma carteira de cigarro foi encontrado certa quantidade de erva similar a maconha. O carro foi apreendido para a adoção das medidas necessárias.
Barragem de Aracatu sangra e traz alívio para a população
15 Abr 2020 // 15:59 Janine Andrade | Agora Sudoeste






















